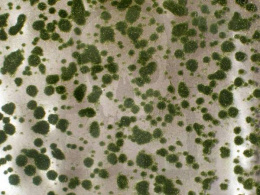
MiniNatur: Tuft - Letnie kępki mchu (42x1 cm)

-
Koszyk jest pusty
-
x
Do bezpłatnej dostawy brakuje
-,--
Darmowa dostawa!
Suma
0,00 zł
Cena uwzględnia rabaty

0,00 zł
0
-
Koszyk jest pusty
-
x
Do bezpłatnej dostawy brakuje
-,--
Darmowa dostawa!
Suma
0,00 zł
Cena uwzględnia rabaty
- Kategorie
- Szukaj
-
Wyprzedaże